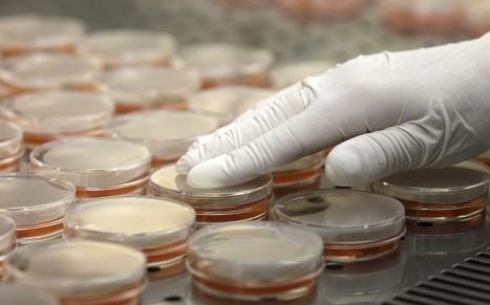
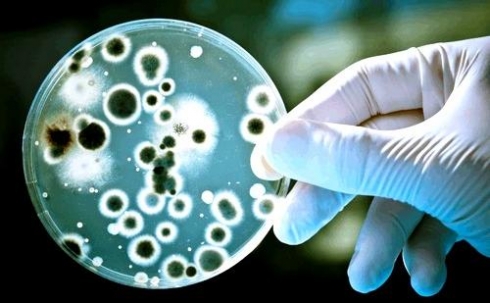

лента БЛОГЕРа
-
Для предотвращения несанкционированного перемещения животных по периметру населенного пункта Еркіндік прорыт ров
По периметру села Еркіндік Карагандинской области прорыт ров для предотвращения несанкционированного перемещения животных, передает Today.kz. Также установлены два блок-поста с дезинфекционным барьером. Площадь работ составила 21 тысячу квадратных метров.
-
Ряд чиновников уволили из-за сибирской язвы в Карагандинской области
Аким Карагандинской области Нурмухамбет Абдибеков провел очередное заседание штаба по профилактике и ликвидации очагов инфекционных заболеваний.
-
Жители села, где произошла вспышка сибирской язвы, попросили уничтожить бездомных кошек и собак
В Департаменте по защите прав потребителей уточнили, что кошек и собак необходимо уничтожить не только из-за просьбы жителей села Еркиндик, но и согласно Правилам, которые используются во вр...
-
Умерших от сибирской язвы захоронили в оцинкованных гробах
На данный момент ситуация в селе Еркиндык под контролем. Проводятся все необходимые карантинные мероприятия. В селе находятся различные специалисты.Напомним, в период с 20 по 23 июня в стаци...
-
Бекшин: "Новых случаев заражения сибирской язвой не выявлено"
Новых случаев заражения сибирской язвой за последние сутки в Карагандинской области не выявлено. Об этом премьер-министру доложил главный санитарный врач страны Жандарбек Бекшин.
-
Погибших от сибирской язвы в Карагандинской области похоронят под слоем извести
По словам руководителя управления здравоохранения Карагандинской области Ержана Нурлыбаева, тела двоих погибших от инфекционного заболевания в селе Еркіндік (предположительно, сибирской язвы), будут захоронены с учетом определенных санитарно-эпидемиологических требований, передает корреспондент Today.kz.
-
Полиция завела уголовное дело в связи с заражением сибирской язвой в Карагандинской области
ДВД Карагандинской области возбудил уголовное дело по факту нарушения ветеринарных правил в связи с последними событиями в селе Еркиндик Шетского района, сообщает корреспондент Tengrinews.kz.
-
В управлении здравоохранения рассказали подробности госпитализации умерших предположительно от сибирской язвы больных
Трудности в определении диагноза умерших предположительно от сибирской язвы пациентов были связаны с предоставлением ими неполных сведений об обстоятельствах заражения. Об этом в ходе пресс-конференции сообщил руководитель управления здравоохранения Карагандинской области Ержан Нурлыбаев.
-
Карагандинская область на 100% готова бороться с сибирской язвой
На пресс-конференции с участием руководителей уполномоченных органов журналистам сообщили, что область на 100% готова бороться с опасным инфекционным заболеванием.
-
Врачи назвали предположительную причину заражения сибирской язвой
Напомним, с 20 по 22 июня в Областную инфекционную больницу были госпитализированы 9 больных из села Еркиндик шетского района с предварительным диагнозом «сибирская язва, кожная форма».
-
Свыше 60 человек наблюдается у врачей из-за сибирской язвы в селе Еркиндик
Напомним, в ночь на 20 июня в Областную инфекционную больницу поступило пять человек с подозрением на сибирскую язву. Все пятеро – жители села Еркиндик, перед тем, как попасть в больницу, имели контакт с мясом больного животного, и поэтому предположительно могли заразиться сибирской язвой. К сожалению, жизни двоих из госпитализированных не удалось спасти. Умершие не были членами одной семьи, однако были соседями.
-
В селе Еркиндик введен режим ЧС в связи с подозрением на сибирскую язву
Известие о возникновении очага возможной инфекционной угрозы в Карагандинской области посеяло беспокойство среди жителей шахтерской столицы. Ранее в областной инфекционной больнице с подозрением на сибирскую язву скончалось два человека.
-
В Караганде экс-директор продал пони и присвоил деньги
Оглашен обвинительный приговор бывшему директору зоопарка Караганды, передает корреспондент Today.kz из зала суда. Абылай Шуланбаев признан виновным в злоупотреблении должностными полн...
-
Экс-директор зоопарка Караганды незаконно продал пони и присвоил деньги
Оглашен обвинительный приговор бывшему директору зоопарка Караганды, передает корреспондент Today.kz из зала суда. Абылай Шуланбаев признан виновным в злоупотреблении должностными полномочиями, но суд освободил его от наказания по причине истечения срока давности - с момента совершения должностного преступления прошло два года.
-
Прокурор просит освободить от уголовного наказания экс-главу зоопарка Караганды
Природоохранная прокуратура в связи с истечением срока давности совершения преступления просит суд освободить от уголовного наказания теперь уже бывшего директора карагандинского зоопарка Абылая Шуланбаева, обвиняемого в незаконных обменах и продаже животных. С такой просьбой к судье в ходе прений обратился государственный обвинитель, передает корреспондент Today.kz.
-
В Карагандинской области создан штаб по контролю за ситуацией, связанной с сибирской язвой
16 июня 2016 года житель Успенского сельского округа населенного пункта «Еркиндик» Шетского района Карагандинской области сообщил сельскому ветеринарному фельдшеру о заболевшем к...
-
Карагандинец выплатит компенсацию морального вреда за прыжок собаки на ребенка
Районный суд Караганды рассмотрел гражданское дело по иску жительницы города, которая потребовала полмиллиона тенге с хозяина собаки. По словам женщины, собака прыгнула на ее ребенка и сильно его напугала, передает Today.kz со ссылкой на пресс-службу районного суда №2 Казыбекбийского района. Карагандинка также утверждает, что ее ребенок в результате инцидента получил травмы.
-
Уже почти два года радует детей и взрослых Контактный зоопарк
С момента открытия общительных животных стало больше, и в скором времени зоопарк ожидает пополнение, пишет газета "Авитрек".


vk
facebook
twitter
ok
mail.ru
instagram
youtube
Объявления
Погода
Медиа
Справочник